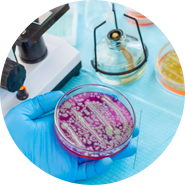

-
- 화장품 수출 필수 서류 국가 별 정리 2025.12.01
- 화장품 유해사례등 안전성 정보 보고 가이드라인 2025.09.01
- 미국 화장품 수출, MoCRA 등록 및 필요서류 2025.07.09
- 유럽 화장품 수출, CPNP 등록 및 필요 서류 2025.07.05
- 중국 완전판 안전성 평가 보고서 의무화 시행에 따른 제출 자료 안내 2025.04.14
2025.1201화장품 수출 필수 서류 국가 별 정리미생물 시험 전문 업체 바이오로드랩입니다.지난 포스팅에서 안전성 평가 제도에 대해서 안내 드렸었는데요.오늘은 앞으로 도입될 국내 화장품 안전성 평가 세부기준과 유럽, 중국의 기준에 대해 알아보도록 하겠습니다.국가별 안전성 평가 세부기준아래 비교표를 보시면 국내 기준(안)과 유럽 및 중국의 기준은 거의 비슷합니다.중국에서는 부록으로 필요한 정보(자료)가 직접적으로 기재되어 있으며, 해당 자료는 국내와 유럽에도 적용됩니다.국내 화장품에도 안전성평가가 2026년부터 도입될 예정이고(2년유예) 그 방향성이 유럽과 중국에 따라 준비되고 있습니다.안전성 평가는 크게 두가지(안전성 정보, 평가)로 구분 됩니다.안전성 정보는 아래와 같습니다.1. 정량/정성 조성 정보 (의도/비의도적 원료 자료)2. 물리화학적 특성3. 안정성 자료4. 미생물 특성 (방부력 시험 자료)5. 불순물/포장재 정보6. 예상한 가능한 제품 사용 방법7. 제품 노출량 정보 (타입, 적용부위, 사용빈도, 대상자, 피부흡수율 ..